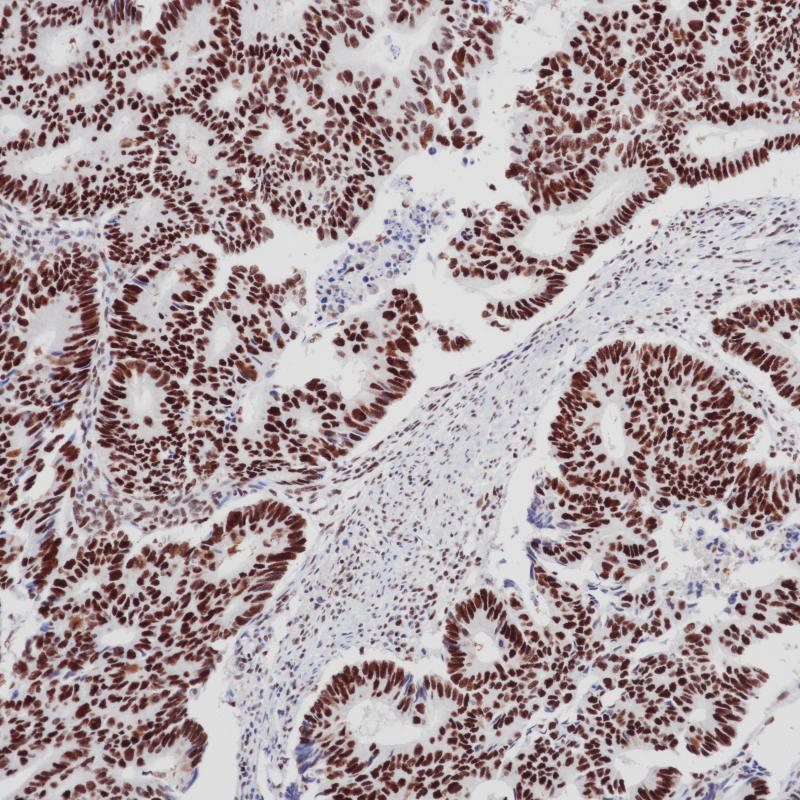
结肠癌 MSH2（BPM6143）染色

产品中心
结肠癌 MSH2(BPM6143)染色

扁桃体 MSH2(BPM6143)染色
MSH2 鼠单克隆抗体
MSH2是一个105kDa的核抗原,编码934氨基酸的蛋白质。MSH2是DNA 错配修复系统中的1种错配修复基因,DNA错配修复系统是人体细胞的一种能修复DNA碱基错配的安全保障体系,是由一系列特异性修复DNA碱基错配的酶分子组成。MSH2基因突变发生在散发性结肠癌中,MSH2突变与50%的遗传性非息肉性大肠癌(HNPCC)相关。MSH2常用于Lynch综合征的免疫组化筛查。
Specifications
- 目录号
- BX50142
- 克隆号
- BPM6143
- 阳性对照
- 扁桃体
- 亚细胞定位
- 细胞核
- 组织类型
- FFPE
- 修复方式
- HIER
- 稀释比
- 1:100-1:200
- 规格
- 100μl/vial, 1ml/vial
- 用途
- RUO
Reference
1.Thibodeau SN, French AJ, et al.Cancer Res 1996 Nov1;56(21):4836-40.
2.National Committee for Clinical Laboratory Standards(NCCLS). Villanova, PA 1991;7(9). Order code M29-P.


